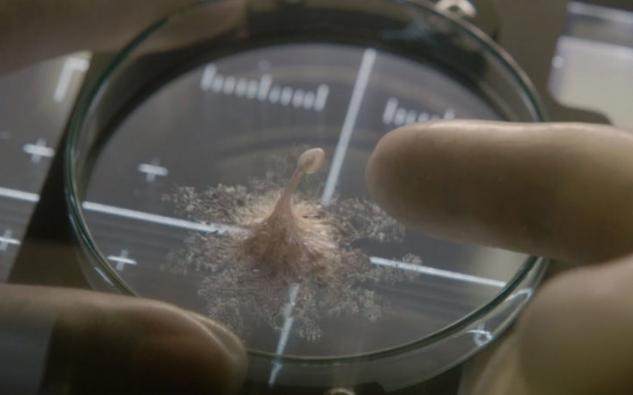

2019-05-01 01:59:00
历史上关于星座的说法有很多,而且几乎每个星座都有一个不同的传说,这些传说有的 ... [详细]
|
最近一部超级恐怖的科幻电影异性就醒上映,很多网友表示在去影院看电影的时候直接吓得全称捂脸,特别是女孩白去影院了一趟了,当然大部分人还是提心吊胆的全程看完了,其中对剧中的一些主要的角色有疑问,比如怪物是怎么死的,以及外星生物叫什么名字,下面资深的异形迷给大家科普一下。
异星觉醒里外星生物叫什么? 叫卡尔文。这个外星生物非常的牛,整体没有要害部位,要想杀死他,需要把他的每一个细胞都得杀死才可以。 异星觉醒里的怪物怎么死的? 当然怪物是没有死的,看过影片的朋友都知道,那个男的去了地球,女的去了外太空,哪些倒霉的渔民一开门把怪物都给放了出来。  外形怪物首先被发现的场景  外形怪物在不断的长大 
|